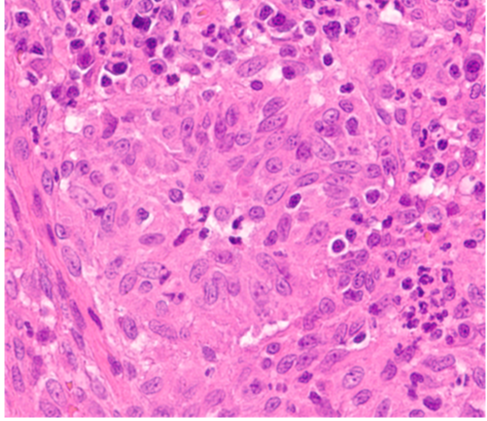
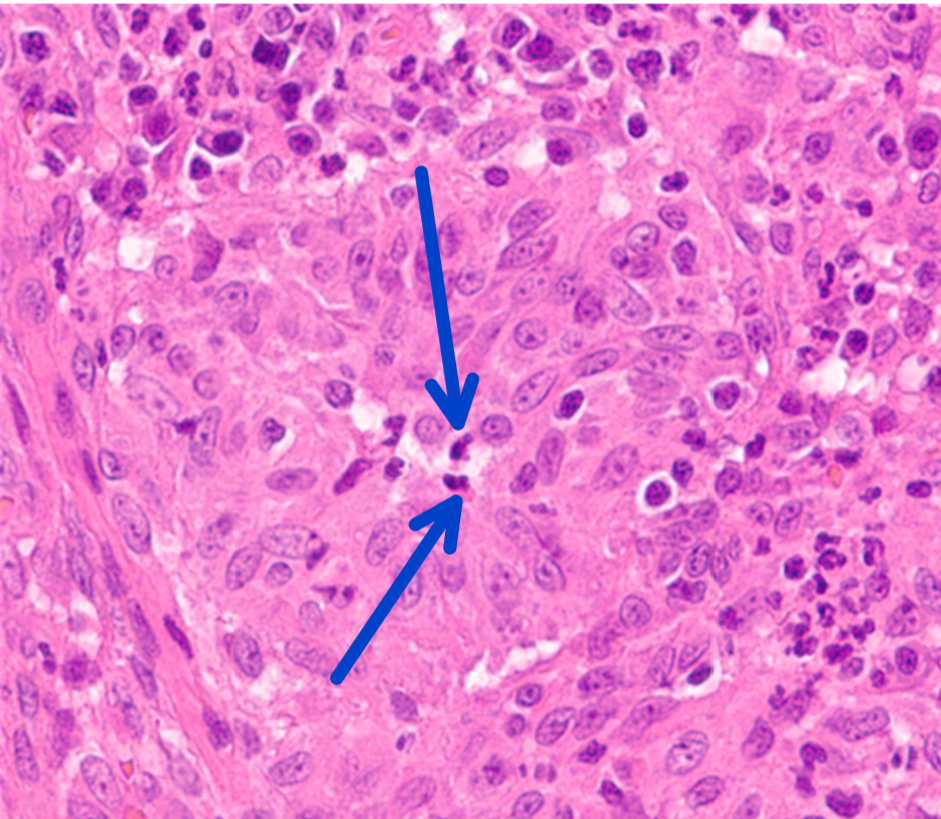
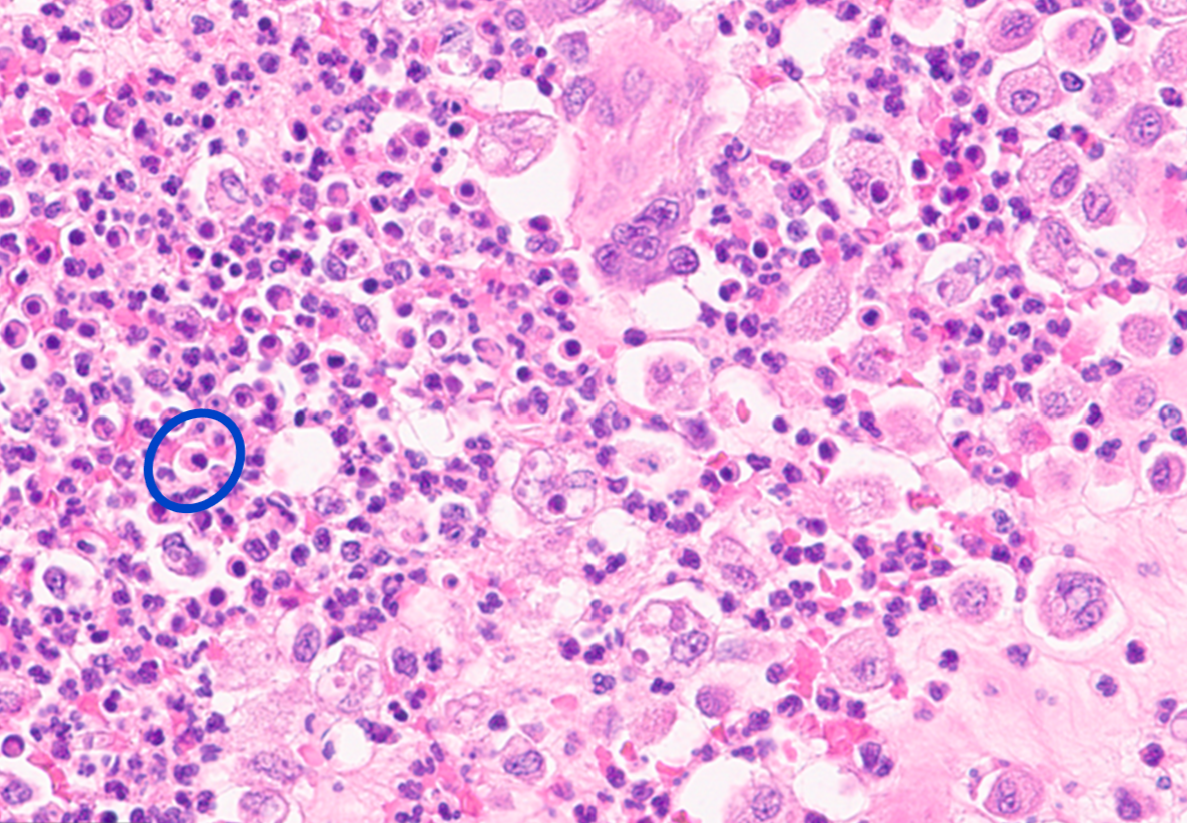
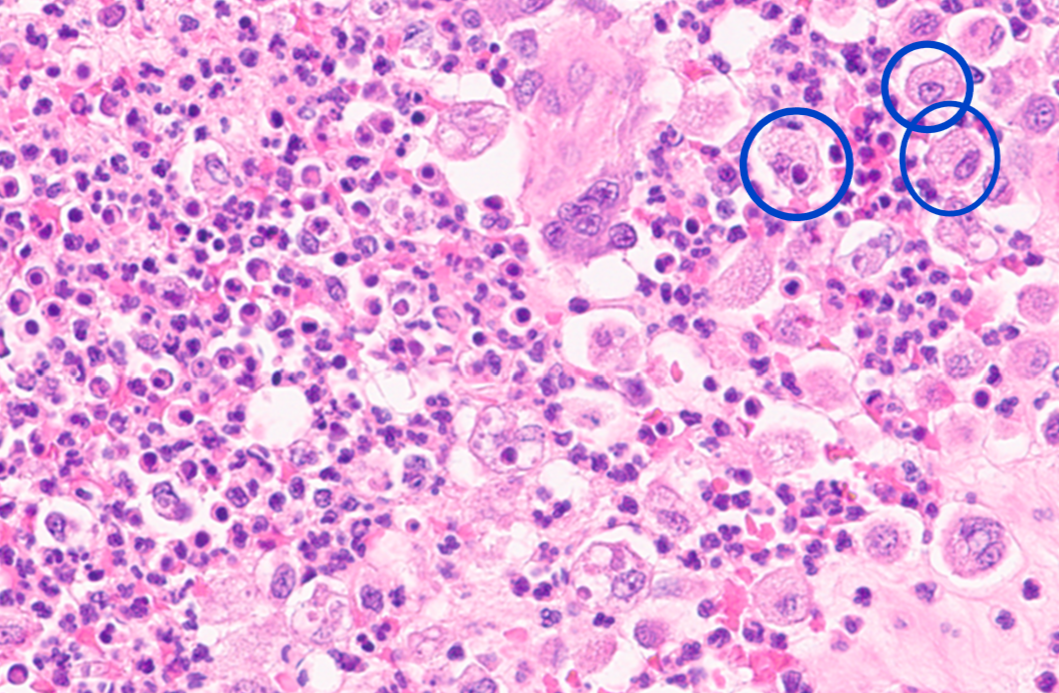
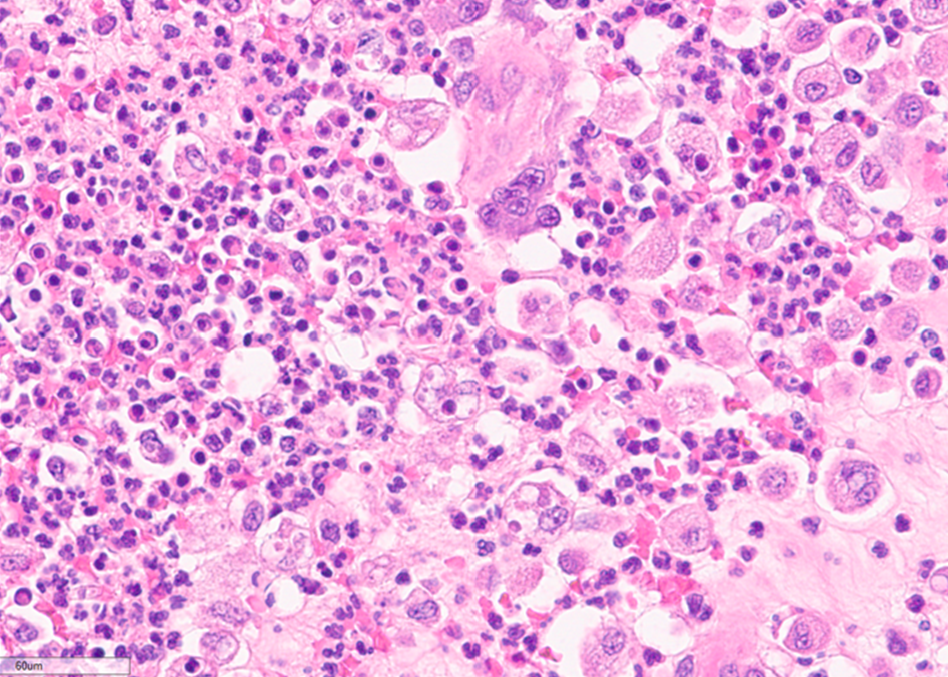

Identify this structure:

granuloma
Identify this structure:

fibrous ring
Identify this structure:

macrophages
Why do fungal agents cause a granulomatous reaction?
fungi have complex call walls that are not easily killed by the killing mechanisms of neutrophils and tend to persist and require macrophages to kill them
What is the histomorphologic diagnosis of this lesion?

severe chronic widely disseminated pyogranulomatous pneumonia
Identify this structure:

multinucleated giant cells
Identify this structure:

heterophils
What type of inflammation is present in this skin mass from the turtle?

heterophilic and granulomatous inflammation
What is this dark staining?

surgical margins
This is a skin mass from a Lab. What cell type are present in this lesion?
macrophages, neutrophils centrally, lymphocytes and plasma cells peripherally
Identify this structure:

acid-fast bacteria
Identify this structure:
neutrophils
This is from a skin mass of a golden.What is the morphological diagnosis for this lesion?

granlomatous or pyogranulomatous dermatitis, focal, chronic, with intramacrophagic acid-fast bacteria
Identify this structure:
plasma cell
Identify this structure:
macrophages
Identify this structure:

neutrophils
Given the population of inflammatory cells here, what type of inflammatory exudate is this?
pyogranulonatous, or purulent and histiocytic
Provide a morphologic diagnosis for this lesion:

chronic, diffuse, severe, granulomatous ileitis
Histologically, what cells are seen in granulomatous inflammation?
predominately macrophages and fewer epitheliod macrophages and multinucleated cells
What is a diffuse granuloma also known as?
lepromatous
Grossly, what do nodular granulomas look like?
gray to white, round to oval, firm to hard, and well demarcated
Grossly, what do tuberculoid granulomas look like?
well delineated, confined distribution, commonly have a fibrous component
An acid-fast stain was performed on this slide from the intestine of a cow, what sort of pathogen is seen taking up stain in the slide?

acid-fast bacteria specifically M. avium in this lesion
What is this?

a fibrous tag



















